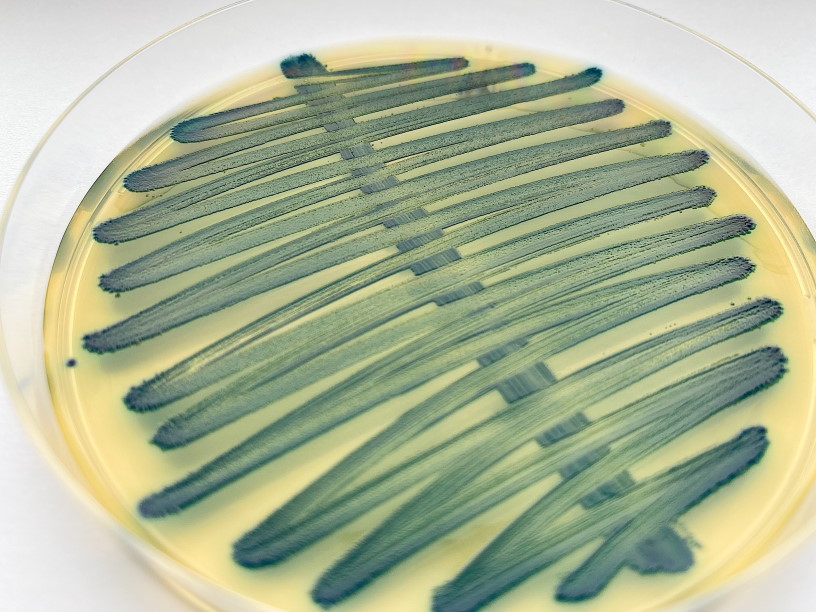

Промикробы: Берегите женщин
Сегодняшних наших героев не вырастить на питательных средах, как ни старайся. Дело в том, что они вирусы. Итак, прошу любить и жаловать — цитомегаловирус (лат. Cytomegalovirus, CMV), род вирусов из подсемейства бетагерпесвирусов семейства герпесвирусов. «Цито» — клетка, «мегало» — большой. Этот вирус повреждает цитоскелет, вызывая значительное увеличение клеток, благодаря чему он и был назван.
⠀
Как вы, возможно, знаете, герпес-вирусы обладают таким противным свойством, как постоянно находиться в организме после однократного заражения. Это называется «персистировать», и цитомегаловирус так тоже делает. Есть несколько разных способов заразиться ЦМВ: воздушно-капельным путём, при поцелуях, половым путём, при переливании крови, при родах и при грудном вскармливании.
⠀
В здоровом организме вирус никак себя не проявляет, но может быть смертельно опасен для людей с иммунодефицитами. У восприимчивых людей срок от 20 до 60 дней считается инкубационным для ЦМВ, тогда как острая фаза заболевания длится от 2 до 6 недель. При этом проявляются повышение температуры тела, признаки общей интоксикации, слабость, ознобы, головные боли, боли в мышцах, явления бронхита. Впоследствии под действием вируса происходит перестройка иммунной системы организма, готовящейся к отражению атаки. Однако в случае нехватки сил организма острая фаза переходит в более спокойную форму, когда зачастую проявляются сосудисто-вегетативные расстройства, а также поражения внутренних органов.
⠀
В данном случае возможны различные проявления заболевания. По сценарию ОРВИ — слабость, общее недомогание, быстрая утомляемость, немного повышенная температура тела, головные боли, насморк. Может произойти поражение органов мочеполовой системы — в виде неспецифического и периодического воспаления. И, наконец, самый страшный сценарий — генерализованная форма. Происходит поражение внутренних органов — печени, надпочечников, почек, селезёнки, поджелудочной железы. Вместе с тем может наблюдаться уменьшение тромбоцитов в периферийной крови, поражение стенок кишечника, сосудов глазного яблока, головного мозга и нервной системы.
⠀
Очень опасен цитомегаловирус для беременных женщин. Он является одной из наиболее частых причин невынашивания плода. Но даже если выносить получилось, заражение плода может привести к поражению нервной системы и головного мозга, что проявляется в различных психологических и физических заболеваниях. Важно, наступило ли заражение беременной женщины впервые или произошла реактивация инфекции: во втором случае вероятность инфицирования плода и развития тяжёлых осложнений существенно ниже.
⠀
Часто цитомегаловирусные инфекции не диагностируются из-за невыраженной симптоматики. Но антитела вырабатываются и сохраняются всю жизнь, в отличие от некоторых других вирусов. Поэтому иммунологические методы работают и позволяют определить, было ли заражение. Для выявления активной инфекции, а не факта заболевания когда-то в прошлом, подходят два метода — культивирование вируса (очень сложно) и ПЦР (гораздо проще). Методом ПЦР цитомегаловирус чаще всего ищут во влагалищных мазках, что абсолютно логично, учитывая все риски и страшные последствия болезни для плода, и в мазках из зева, так как ОРВИ — частая форма проявления ЦМВ.
⠀
Цитомегаловирус обнаружен практически во всех точках земного шара и распространен среди всех социоэкономических групп. По данным исследователей, в возрасте от 6 лет и старше около 60 % исследуемых инфицированы ЦМВ. А в возрасте 80 лет и старше уже 90 % являются сероположительными.